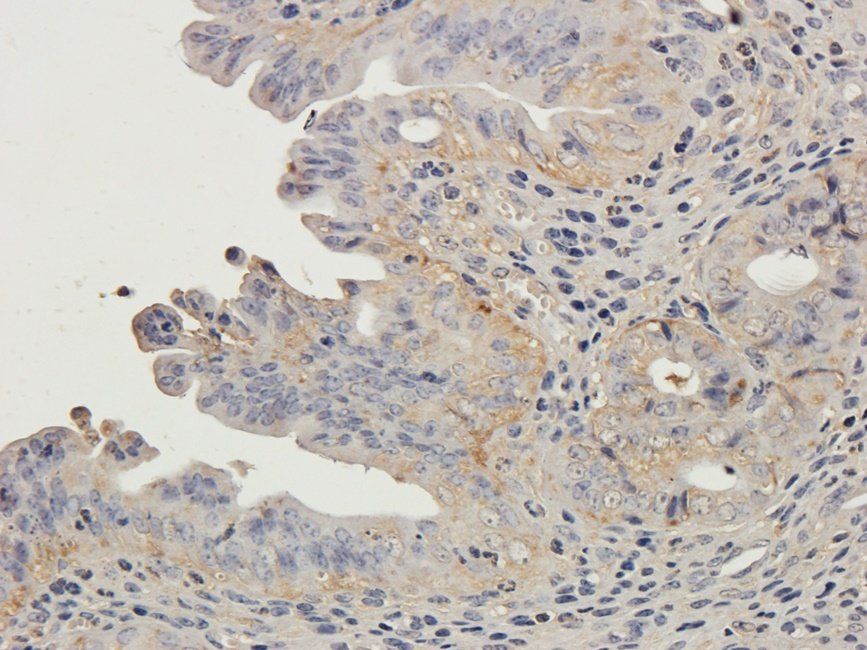
LTBP4 Rabbit Polyclonal Antibody
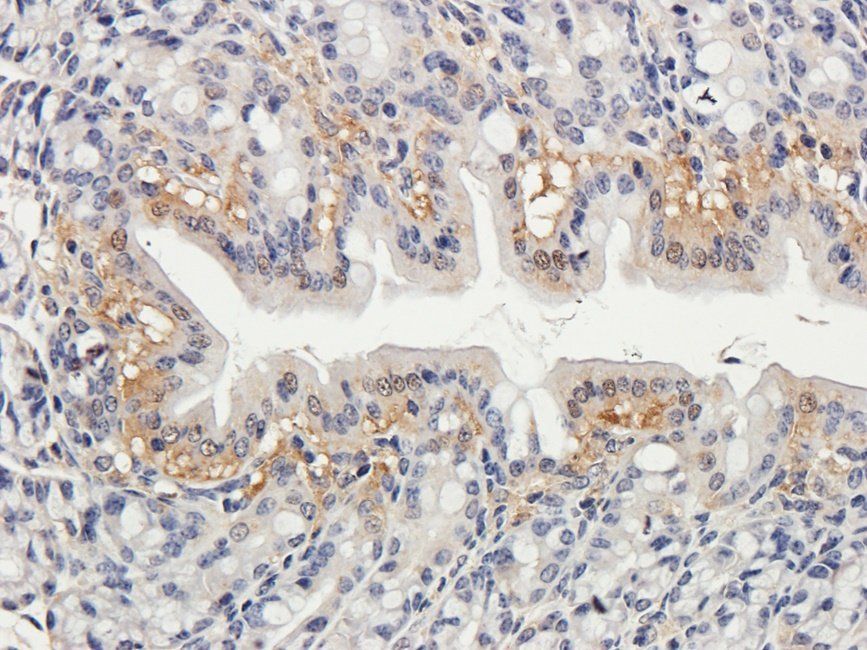
Neuroplastin Rabbit Polyclonal Antibody

You have no items in your shopping cart.
All Products
- Featured
LTBP4 Rabbit Polyclonal Antibody [orb19458]Featured
ICC, IF, IHC-P, WB
Human, Mouse, Rat
Rabbit
Polyclonal
Unconjugated
100 μg - Featured
Neuroplastin Rabbit Polyclonal Antibody [orb19499]Featured
ICC, IF, IHC-P, WB
Guinea pig, Human, Mouse, Rat
Rabbit
Polyclonal
Unconjugated
100 μg - Featured
EPAS1 Rabbit Polyclonal Antibody [orb19610]Featured
ICC, IF, IHC-P, WB
Guinea pig, Human, Mouse, Rat
Rabbit
Polyclonal
Unconjugated
100 μg - Featured
SERPING1 Rabbit Polyclonal Antibody [orb101493]Featured
ELISA, IHC-P, WB
Human, Mouse, Rat
Rabbit
Polyclonal
Unconjugated
100 μg, 500 μg - Featured
Syncytin 1 Rabbit Polyclonal Antibody [orb100573]Featured
ELISA, IHC-P, WB
Rabbit
Polyclonal
Unconjugated
100 μg - Featured
RGCC Rabbit Polyclonal Antibody [orb422562]Featured
IHC-P, WB
Guinea pig, Human, Mouse, Rat
Rabbit
Polyclonal
Unconjugated
100 μg - CTSD Antibody [orb1410244]
IHC, WB
Human
Mouse
Monoclonal
Unconjugated
20 μg, 100 μg, 100 μg (without BSA and Azide) - SOX4 Antibody [orb1410067]
FC, IF, IHC, WB
Human
Mouse
Monoclonal
Unconjugated
20 μg, 100 μg, 100 μg (without BSA and Azide) - GFAP Antibody [orb2310005]
IHC, WB
Human
Mouse
Monoclonal
Unconjugated
20 μg, 100 μg (without BSA and Azide), 100 μg - Featured
NCL Antibody [orb388512]Featured
FC, IF, IHC, WB
Human
Mouse
Monoclonal
Unconjugated
20 μg, 100 μg, 100 μg (without BSA and Azide)